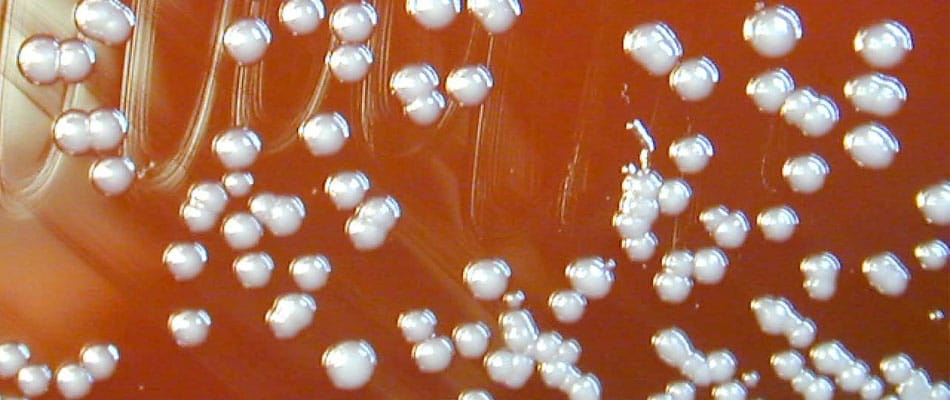
Ces dangereuses bactéries dont on perd la trace Ces dangereuses bactéries dont on perd la trace

La description fait penser à un film d’horreur : une bactérie dangereuse et souvent mortelle s’est échappée d’un laboratoire à haute sécurité. Heureusement, la réalité reprend vite le pas sur la fiction.
Si elle ne pose pas de danger pour le public, son « évasion » n’en demeure pas moins un mystère, a d’abord longuement rapporté le USA Today dimanche. Comme il s’agit d’une bactérie qui vit dans le sol et l’eau dans le sud de l’Asie et le nord de l’Australie, les responsables du Centre de recherche sur les primates, en Louisiane, présument qu’elle aurait pu s’échapper du laboratoire pour contaminer le sol de l’établissement, et de là, contaminer quatre singes rhésus qui ne sont pas impliqués dans ces recherches.
Ça n’explique toutefois pas comment cette bactérie a pu s’échapper. Et cet incident s’ajoute à d’autres survenus dans la dernière année : la découverte, au fond d’un entrepôt médical du Maryland, de fioles contenant le virus de la variole, une maladie éradiquée depuis 40 ans. Et puis, la découverte de fioles de ricine et de peste « incorrectement entreposés » dans des édifices des National Institutes of Health. Le tout, dans un pays, les États-Unis, à la fine pointe de la science, qui dépense plus que tous les autres pays réunis pour assurer sa (bio)sécurité.
Selon les informations qui ont filtré, la bactérie burkholderia pseudomallei, (bacille de Whitmore) aurait infecté les singes dès novembre. Elle peut se transmettre aux humains et aux animaux par simple contact avec du sol ou de l’eau contaminés. Elle cause une maladie appelée mélioïdose-fièvre, maux de tête, perte d’appétit, etc. — endémique en Asie et parfois mortelle.
Il est également fait mention d’une enquêteuse du ministère fédéral de l’Agriculture qui aurait été contaminée en janvier, « 24 heures après avoir visité l’établissement », encore qu’on semble hésiter à affirmer si la contamination provient du laboratoire « ou de ses voyages à l’étranger ».
Les recherches en Louisiane, à présent suspendues, visaient à développer un vaccin contre cette bactérie, mais les expériences portaient sur des rongeurs à l’intérieur du laboratoire à haute sécurité (dit de niveau 3), et non sur les singes, qui vivent à l’extérieur.
L’enquête sur cette « fuite » était en cours depuis quelques semaines lorsque les médias en ont eu vent. Pour un expert en biosécurité interrogé par le USA Today — et qui avait témoigné devant le congrès l’an dernier à propos des découvertes inopinées de fioles de varioles — l’élément inquiétant de cette affaire n’est pas tant la fuite, que le fait « qu’ils ne peuvent pas identifier comment cette fuite s’est produite ».